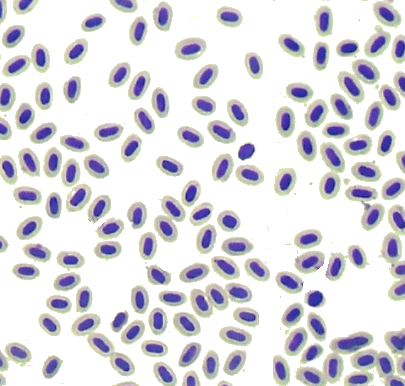

Haematology & Biochemistry:
In order to maximize the information gained per sample, WBR also offers Hematology and Biochemistry analytical services for zebrafish, rodents & Non-Rodents.
Hematology (complete blood count (CBC)
- Total leukocyte count
- Erythrocyte count
- Hemoglobin
- Hematocrit
- Mean corpuscular volume
- Mean corpuscular hemoglobin
- Mean corpuscular hemoglobin concentration
- Red Cell Distribution Width
- Platelet count
- Differential leukocyte counts
- Nucleated red blood cell count
- Reticulocytes
- Red blood cell, white blood cell and platelet morphology
Complete Biochemical Profile:
- Glucose
- Blood Urea nitrogen (BUN)
- Creatinine
- Creatine kinase (CK)
- Total Protein
- Albumin
- Globulins
- Na, Cl, K, PO4, Ca, Fe, Mg
- Total CO2
- Cholesterol
- Triglycerides
- Total Bilirubin
- Alkaline Phosphatase (ALP)
- Alanine Transaminase (ALT)
- Gamma Glutamyl transferase (GGT)
- Aspartate aminotransferase (AST)
- Lactate dehydrogenase (LDH)
- Non-Esterified Fatty Acid (NEFA)
Urinalysis:
- Appearance (color, clarity)
- Total volume
- Specific gravity
- Reagent strip
- pH
- Bilirubin
- Ketones
- Protein
- Glucose
- Blood
- Urine sediment (microscopic analysis)
Coagulation:
- Prothrombin time
- Activated partial thromboplastin time
- Fibrinogen
Urine Biomarker
- NAG (N-acetyl-β-D-glucosaminidase)
- GGT
- UPC (Urine protein:creatinine)
- Urine Electrolytes (Na and K)
- Urine Creatinine (Enzymatic)
Lipid profile:
- Triglycerides
- HDL
- LDL
- Cholesterol
- Glucose
- NEFA (Non-esterified Fatty Acids)